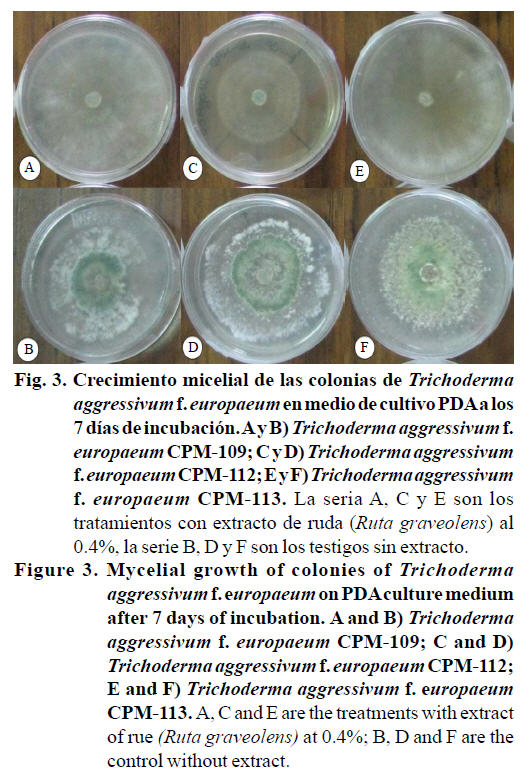

Servicios Personalizados
Revista
Articulo
Indicadores
-
Citado por SciELO -
Accesos
Links relacionados
-
Similares en
SciELO
Compartir
Revista mexicana de ciencias agrícolas
versión impresa ISSN 2007-0934
Rev. Mex. Cienc. Agríc vol.5 no.8 Texcoco nov./dic. 2014
Artículos
Efecto del extracto de ruda (Ruta graveolens) en el crecimiento micelial de Trichoderma*
Effect of the extract of rue (Ruta graveolens) on the mycelial growth of Trichoderma
Claudia Katia Reyes-Quintanar1*, Daniel Martínez-Carrera1§, Porfirio Morales Almora1, Mercedes Sobal Cruz1, Alan Helios Escudero-Uribe1 y José Guillermo Ávila-Acevedo2
1 Colegio de Postgraduados, Campus Puebla, Biotecnología de Hongos Comestibles, Funcionales y Medicinales, A. P. 129, Puebla 72001, Puebla, México. *Becaria del CONACYT (no. 100054), doctorado. (ckatiarq@colpos.mx). §Autor para correspondencia: dcarrera@colpos.mx..
2 UNAM, Unidad de Biotecnología y Prototipos, Facultad de Estudios Superiores Iztacala, Laboratorio de Fitoquímica, Avenida de los Barrios Número 1, Colonia Los Reyes Iztacala Tlalnepantla, Estado de México, C. P. 54090.
* Recibido: febrero de 2014
Aceptado: junio de 2014
Resumen
Uno de los principales problemas en el cultivo de hongos comestibles es la contaminación causada por el moho verde Trichoderma, el cual se caracteriza por ser de rápido crecimiento, altamente competitivo y provoca grandes pérdidas en la producción mundial de hongos cultivados. Actualmente, se utilizan fungicidas químicos para contrarrestar la contaminación en plantas productoras. La planta de ruda (Ruta graveolens) es una planta aromática que produce diversos metabolitos secundarios con propiedades fungicidas. Debido a lo anterior, el objetivo del presente estudio fue evaluar el efecto del extracto etanólico de ruda en el desarrollo y producción de esporas del moho Trichoderma aggressivum f. europaeum. Para el presente estudio, se utilizó material vegetal del Jardín Etnobotánico de San Andrés Cholula, Puebla, cosechado en agosto de 2011. Se realizó un extracto etanólico de ruda y se suspendió en agua destilada estéril, se filtró para su esterilización y se agregó al medio de cultivo PDA en una concentración de 0.4%. Se evaluaron: crecimiento micelial, conteo y germinación de esporas de T. aggressivum f. europeaum. Se observó una inhibición en la velocidad de crecimiento micelial de las cepas de Trichoderma expuestas al extracto de ruda. También se observó una menor proporción de germinación de esporas expuestas directamente al extracto. La esporulación de Trichoderma a partir de la germinación de esporas en el medio con ruda fue menor que el testigo. El extracto de ruda disminuyó la densidad micelial de las cepas estudiadas. Los resultados demostraron que se puede inhibir el crecimiento (53%-81%), la esporulación y la germinación de Trichoderma en niveles superiores al 90% empleando extractos vegetales naturales, los cuales pueden ser potencialmente utilizados en el cultivo de hongos comestibles.
Palabras clave: antifúngico, extracto, Ruta graveolens, Trichoderma aggressivum f. europaeum.
Abstract
One of the main troubles in edible mushroom cultivation is contamination by the green mold Trichoderma, which is aggressive and easily spread on the substrate competing for space and nutrients. Currently, chemical fungicides are used to control it during mushroom cultivation; however, the use of chemicals is increasingly banned by society due to their toxicity and persistence in the environment. Rue (Ruta graveolens) is an aromatic plant capable of producing secondary metabolites with antifungal properties. For this reason, the objective of this study was to assess the effect of R. graveolens ethanolic extract on in vitro mycelial growth and spore production of Trichoderma aggressivum f. europeaum. For this research we used plant material obtained from the Ethnobotanical Garden of San Andrés Cholula, Puebla, harvested in August, 2011. We made an ethanolic extract of rue, diluted in sterilized distilled water, filtered for sterilization and it was added into the PDA medium at a 0.4% concentration. Assessing Mycelial growth rate, sporulation and spore germination of T. aggressivum f. europeaum. Inhibition was observed in the rate of mycelial growth of Trichoderma strains exposed to the rue extract. Sporulation of Trichoderma from spore germination in the medium with rue was lower than the control. The rue extract decreased the mycelial density of Trichoderma strains. The results showed inhibition of mycelial growth (53%-81%), as well as sporulation and spore germination of Trichoderma up to 90%, using a natural plant ethanolic extract, which may be potentially used during mushroom cultivation.
Keywords: antifungal, extract, Ruta graveolens, Trichoderma aggressivum f. europaeum.
Introducción
Un problema frecuente y de gran importancia en el proceso de cultivo de la mayoría de los hongos comestibles son los problemas de contaminación, principalmente por los mohos que proliferan por las condiciones de humedad y temperatura, así como de sanidad ambiental local, necesarias para el desarrollo y fructificación de los hongos comestibles. La mayoría de los mohos que atacan al cultivo de hongos comestibles provocan diferentes tipos de putrefacción del sustrato (blanda o seca), y son principalmente del género Trichoderma (Oei, 1991). Es muy común encontrarlo en el compost o sustrato, inhibiendo y reduciéndo la fructificación, así como parasitando los carpoforos cultivados. Algunas especies de Trichoderma se desarrollan en tejidos leñosos, son abundantes en la turba y se les localiza frecuentemente en los cajones de madera que contienen el compost que sirve de cama para el cultivo de hongos comerciales.
Hoy día; sin embargo, este último hecho es poco frecuente debido a los avances tecnológicos de cultivo, al difundirse cada vez más el uso de anaqueles metálicos (hierro galvanizado o aluminio). Si existen puntos de contaminación en el lugar de cultivo de hongos comestibles el Trichoderma, suele diseminarse fácilmente por vía aérea a través de la vestimenta de los cultivadores durante las labores de cosecha y limpieza de las camas de sustrato o bien por vía húmeda mediante las labores de riego (Stamets y Chilton, 1983). Se han realizado diversos estudios para el control del moho verde en el cultivo de los hongos comestibles (Przybylowies y Donoghue, 1990; Stamets, 2000; Guzmán et al., 2002), encontrándose entre otras estrategias utilizadas el control ambiental.
Sin embargo, a pesar del estricto manejo de los factores físicos, la presencia del Trichoderma spp. continua causando daño a diversos cultivos de hongos comestibles alrededor del mundo. Actualmente, se aplican prácticas de manejo y control de plagas con fungicidas tradicionales, los cuales son tóxicos para la salud humana; sin embargo, existen alternativas naturales que pueden ayudar a controlar estos problemas.
Diversas plantas medicinales con propiedades fungicidas representan un gran potencial que podría ser aprovechado en prácticas de cultivo de los hongos comestibles. No obstante lo anterior, existen pocas investigaciones vinculadas al respecto en la aplicación de productos naturales con propiedades antifúngicas dirigidos al cultivo de hongos comestibles. Con base en lo anterior, el objetivo principal del presente estudio fue evaluar el efecto del extracto de ruda (Ruta graveolens) para controlar o inhibir el desarrollo micelial y esporulación del moho verde (Trichoderma).
Materiales y métodos
Material vegetal. Se adquirió 1 kg de ruda (Ruta graveolens) en el Jardín Etnobotánico de San Andrés Cholula Puebla, las cuales fueron cultivadas en compost orgánico, elaborado in situ. Con la planta se realizó una limpieza superficial en seco, con el fin de eliminar plantas ajenas e insectos. Se deshidrató a temperatura ambiente a la sombra durante 15 días. Una vez deshidratado el material se tomó el peso seco y se fragmentó el material en trozos de aproximadamente 1 cm de largo.
Método de extracción. Se utilizó la técnica de maceración en frascos de vidrio de 3.78 L de capacidad. Se colocó el material deshidratado en un recipiente de vidrio y se agregaron aproximadamente 2 L de solvente etanol al 96 °GL con el objetivo de cubrirlo completamente, se maceró por 24 h a temperatura ambiente, se decantó y filtró con papel filtro Whatman No. 40. Tras cubrirse nuevamente con solvente, el material se maceró por otras 24 h para un segundo y un posterior tercer filtrado. El extracto filtrado previo a su evaporación se mantuvo en obscuridad a 4 °C. Una vez obtenido el total del extracto, se concentró en un rotavapor marca Heidolph Laborota 4000 efficient, WBeco a 100 rpm a menos de 40 °C. Obtenido el rendimiento del extracto final, después de su secado a temperatura ambiente, se le mantuvo en refrigeración a 4 ºC hasta su uso.
Pruebas microbiológicas. Para evaluar las cepas de Trichoderma se empleó medio de cultivo PDA, marca BIOXON, con una concentración de 0.4% de extracto de ruda. El extracto se resuspendió en 30 ml de agua destilada estéril en un agitador rotatorio MAXQ 4000 a 110 rpm en 35 °C por 45 min. Se centrifugó en una centrifuga marca Brinkmann 5415C a 10 000 rpm, por 5 min. El extracto se decantó y se filtró en condiciones de esterilidad con acrodisco hidrofílico DISMIC-25 AS, marca Advantec de 0.20 µm para su esterilización, incorporándolo al medio de cultivo tibio. Las cepas empleadas en este estudio provinieron de la colección del Colegio de Postgraduados en Ciencias Agrícolas, Campus Puebla, sección competidores Trichoderma aggressivum f. europaeum (CPM-109), Trichoderma aggressivum f. europaeum (CPM-112), Trichoderma aggressivum f. europaeum (CPM-113), las cuales fueron previamente aisladas de compost de cultivo de Agaricus, de la planta El Riojal, en Xalapa Veracruz. Para evaluar el crecimiento micelial, se inocularon las cajas en medio de cultivo PDA con extracto de ruda al 0.4%. Se colocó un disco de micelio de 0.5 cm de diámetro con 4 días de desarrollo previo en el centro de la caja y se midió el desarrollo micelial de forma radial cada 24 h por 8 días.
Prueba de germinación de esporas. A partir de cepas de Trichoderma que no habían sido expuestas al extracto de ruda previamente, se preparó una suspensión de esporas de cada una de las cepas, se determinó la cantidad de esporas con cámara de New Bauer, se realizaron diluciones y se obtuvo una concentración de 50 esporas en 50 µl. Esta alícuota se distribuyó en condiciones de esterilidad mediante raspado de la placa de agar, usando varilla de vidrio en medio PDA con 0.4% de extracto de ruda. El conteo de esporas germinadas fue individual por caja, mediante observaciones con un microscopio estereoscópico marca ZEISS cada 24 h.
Efecto de inhibición (%). La inhibición en la velocidad de crecimiento micelial y en la germinación de esporas, se calculó en base a Kordali et al. (2008) utilizando la siguiente fórmula:
(%) inhibición= (C - T / C) * 100
Donde: C= promedio de cinco réplicas del crecimiento micelial (cm) de los controles; T= promedio de cinco réplicas del crecimiento micelial (cm) de los tratamientos con extracto.
Conteo de esporas. A partir del crecimiento micelial y en la prueba de germinación de esporas, se efectuó un conteo diario de las esporas en la cámara New Bauer, cuando el micelio de los mohos Trichoderma ha alcanzado al quinto día el borde perimetral de las cajas. El conteo se llevó a cabo cada 24 h durante 8 días, con tres repeticiones por caja. De una caja se tomaron 4 sacabocados de 0.5 mm de diámetro, dos de la periferia y dos del centro; los cuales se colocaron en un tubo con 10 ml de agua destilada estéril con tween al 0.05% (Saxena et al., 2001). El tubo con las muestras se agitó en vortex por 10 segundos y se tomó una alícuota para la lectura en la cámara de New Bauer.
Estadísticos. Se realizó un análisis de varianza (ANOVA) completamente al azar con α= 0.05% y 10 repeticiones. Se utilizó el programa Statistical Analysis System (SAS) versión 9.0.
Resultados y discusión
Velocidad de crecimiento micelial: para la cepa T. aggressivum f. europaeum CPM-109 (Figura 1A), se observó un efecto inhibitorio de la velocidad de crecimiento micelial por el extracto de ruda, principalmente las primeras 24 h con una inhibición del 66% (Fig. 2B); sin embargo, el efecto no fue tan evidente como en las otras dos cepas evaluadas. En cuanto a la cepa T. aggressivum f. europaeum CPM-112 (Figura 1B), la inhibición sobre la velocidad de crecimiento micelial fue significativa con respecto al testigo desde el día 1 hasta el día 5 con una proporción de inhibición de 81.4% al día 1 y hasta 51.9% al día 3 (Fig 2B), llegando a colonizar completamente la caja de Petri hasta los 6 días, dos días después que el testigo. Para la cepa T. aggressivum f. europaeum CPM-113 (Figura 2A), se observó un efecto significativo de inhibición sobre la velocidad de crecimiento micelial por efecto del extracto de ruda en los días 1 y 2, siendo de 53.6% y 44%, respectivamente (Fig. 2B). El punto máximo de crecimiento para el testigo se alcanzó a los 3 días y el tratamiento con extracto también cubrió la caja dos días después.
Esta inhibición en el desarrollo micelial concuerda con estudios previos donde se comprobó que los compuestos antifúngicos 5- y 8-methoxypsoralen aislados de R. graveolens, mostraron un efecto inhibitorio en el desarrollo micelial de los hongos filamentosos Rhizoctonia solanii, Fusarium spp., y Trichoderma viride (Ojala et al., 2000). En general, se pudo observar un efecto inhibitorio de la velocidad de crecimiento micelial de las cepas de Trichoderma evaluadas expuestas al extracto de R. graveolens, en la concentración de 4 mg/ml (Figura 3), principalmente sobre la cepa de T. aggressivum f. europaeun (CPM-112).
Esto puede deberse a que R. graveolens contiene diversos metabolitos secundarios como cumarinas, furanocumarinas y alcaloides con actividad fungicida (El-Sayed et al., 2000; Oliva et al., 2003). Existen registros de inhibición de la velocidad de crecimiento micelial a partir de extractos de R. graveolens y de sus compuestos puros contra hongos filamentosos como Fusarium oxysporum, Botrytis cinerea, Phomopsis viticola y Trichoderma viridae (Oliva et al., 1999; Ojala et al., 2000). Este retraso en la velocidad de crecimiento micelial del Trichoderma es importante para los primeros días del establecimiento micelial de los hongos comestibles, ya que es una etapa crucial donde el cultivo es más vulnerable a contaminación por mohos competidores del tipo de Trichoderma.
Esporulación de Trichoderma a partir del crecimiento micelial: una vez que el micelio colonizó completamente la caja de Petri en medio PDA con extracto, comenzó el conteo de esporas antes de la esporulación de la colonia (a partir del tercer día). En la figura 4A-C, se observa que no hubo una diferencia estadística en la cantidad de esporas con respecto al testigo durante el experimento de ninguna de las tres cepas de Trichoderma evaluadas. Esto pudo deberse a que las cepas se mantuvieron expuestas al medio con extracto de R. graveolens y tuvieron tiempo suficiente para adaptarse a los compuestos del extracto y recuperaron su desarrollo en cuanto a la producción de esporas.
Se sabe que el género Trichoderma tiene una alta capacidad para degradar diversos compuestos del sustrato donde se desarrolla. Su metabolismo enzimático tiene la capacidad de degradar una amplia variedad de substratos, que van desde celulosa hasta compuestos inorgánicos como diversos plaguicidas, incluidos herbicidas, organoclorados e insecticidas organofosforados (Colina et al., 2009; Argumedo-Delira et al., 2009). Esta capacidad metabólica pudo interferir en la rápida adaptación de los componentes orgánicos del extracto evaluado. En el caso de la cepa de T. aggressivum f. europaeum CPM-112, el tratamiento de R. graveolens redujo la velocidad de crecimiento en los días 5 y 6, en comparación con la velocidad del crecimiento micelial del testigo. Entre las tres cepas evaluadas de Trichoderma, la cepa con mayor esporulación a lo largo del experimento fue la de T. aggressivum f. europaeum, CPM-113 (Figura 4C). A pesar de la variabilidad de la cantidad de esporas para los últimos días del muestreo, se observó que la cinética de esporulación el tratamiento con extracto de ruda se mantuvo por debajo del testigo al menos hasta el sexto día para las cepas de T. aggressivum f. europaeum CPM-109 y CPM-112.
Germinación de esporas de Trichoderma y su esporulación: para la prueba de germinación de esporas se colocaron esporas que no habían sido expuestas al extracto de R. graveolens, con la finalidad de observar el efecto del extracto sobre la de germinación de esporas con respecto al testigo. Posteriormente se realizó un conteo del número de esporas producidas por las colonias que confluyeron y esporularon. El efecto del extracto de R. graveolens sobre la germinación de las esporas de T. aggressivum f. europaeum sobre el medio de cultivo se muestra en la Figura 5A-C, donde se observa que el tratamiento con extracto inhibió la germinación, principalmente para la cepa T. aggressivum f. europaeum CPM-112. El conteo de las esporas germinadas se detuvo a los 4 días después de inoculadas, cuando las esporas germinadas colonizaron de micelio completamente la caja de Petri.
Para la cepa T. aggressivum f. europaeum CPM-109 (Figura 5A) si hubo una diferencia significativa de inhibición en la germinación con respecto al testigo hasta el segundo día del experimento, sin embargo desde el tercer día la variabilidad del conteo no permitió una diferencia significativa. En cuanto a la cepa T. aggressivum f. europaeum CPM-112 (Figura 5B), se observó un efecto significativo en la inhibición de la germinación de esporas con una inhibición de 42.1% para el día 2, 64.9% para el día 3 y 70% en el día 4. El efecto inhibitorio en la germinación de esporas puede deberse a que existen registros previos de la presencia de diferentes alcaloides con propiedades antifúngicas aislados de la planta de R. graveolens, como son la quinolina y quinolona los cuales han demostrado tener efectos significativos en contra de diversos hongos filamentosos (Oliva et al., 2003).
En cuanto a la cepa T. aggressivum f. europaeum CPM-113 (Figura 5C), el mayor efecto inhibitorio se observó a los 2 días con 66.4%, el cual se igualó con el testigo a partir del tercer día. En comparación entre las tres cepas evaluadas de T. aggressivum f. europaeum, la cepa CPM-113 resultó ser la más tolerante al extracto de R. graveolens, ya que a pesar de inhibir su velocidad de crecimiento en 53.7% al día 1 con respecto al testigo evaluado, no disminuyó lo suficiente la capacidad de las esporas para germinar en el medio de cultivo.
En el caso del conteo de esporas que se llevó a cabo a partir de las pruebas de germinación, una vez que las esporas de T. aggressivum f. europaeum germinaron y colonizaron completamente la caja de Petri (quinto día), se evaluó el efecto del extracto de R. graveolens con 4 mg/ml sobre la esporulación (Figura 6A-C). Para la cepa T. aggressivum f. europaeum CPM-109 (Figura 6A) con presencia del extracto de R. graveolens se observó una menor concentración del esporas a lo largo del experimento, con un aumento a partir del día 7. En cuanto a la cepa T. aggressivum f. europaeum CPM-112 (Figura 6B), el efecto del extracto sobre la disminución en el número de esporas fue muy similar a las cepas T. aggressivum f. europaeum CPM-109, siendo un comportamiento de esporulación muy por debajo del testigo (Figura 8) en promedio de las 10 réplicas evaluadas.

En la cepa T. aggressivum f. europaeum CPM-113 (Figura 6C), también se observó una inhibición significativa en la germinación, al igual que en las otras dos cepas evaluadas. La cantidad de esporas encontrada para las tres cepas se observa que se mantuvieron muy por debajo del testigo, el efecto de inhibición en la cantidad de esporas encontradas fue de arriba de 90% al día 7 para las 3 cepas de Trichoderma (Figura 7). La variabilidad de los datos en los conteos, principalmente en el testigo, se debe a la heterogeneidad del crecimiento en la caja Petri, ya que el crecimiento desde diversos puntos de germinación por la distribución de las esporas no permitió el crecimiento radial característico de la cepa (Figura 8), influyendo en la zona de muestreo de cada caja. Estos resultados inhibitorios pueden deberse a más de 15 compuestos registrados en la literatura con propiedades antifúngicas provenientes de la planta R. graveolens, entre ellos se encuentran los alcaloides acridona, cumarinas, furanocumarinas, flavonoides, entre otros, así como también aceites esenciales los cuales también tienen el efecto de inhibir la germinación y la velocidad de crecimiento radical de diversas plantas (Oliva et al., 2003; Hale et al., 2004).
En cuanto a la morfología de las cepas de Trichoderma, se observó un efecto del extracto sobre el color de las colonias de la cepa de T. aggressivum f. europaeum CPM-109, ya que el testigo presentó esporas amarillas, a diferencia de aquellas observadas en el tratamiento con extracto de R. graveolens que fueron verde olivo intenso. La cepa expuesta al extracto mostró una coloración más obscura pasando del blanco del micelio a un color verde olivo. En cambio, el testigo mostró una coloración que paso del blanco del micelio a un tono amarillo verdoso intenso para posteriormente tomar un color verde olivo. Esto contradice a la coloración registrada en la literatura ya que menciona que en su desarrollo no existen pigmentos amarillos. A pesar del color, la velocidad de crecimiento micelial coincide con los parámetros descritos en la literatura, ya que se observó micelio de textura algodonosa con bordes regulares, los conidios estuvieron presentes tanto en medio como alrededor del margen de la caja y no hubo tendencia a formar pústulas (Samuels et al., 2002). A pesar de la maduración de las esporas, se observó que la densidad micelial fue menor en el tratamiento de R. graveolens con respecto al testigo y el tipo de crecimiento micelial se observó postrado.
En cuanto a la cepa T. aggressivum f. europaeum CPM-112, se observaron diferencias en la distribución de las esporas, donde el tratamiento con extracto de R. graveolens presentó las esporas principalmente en el centro de la colonia, mientras que en el testigo se observaron esporas dispersas en forma radial hacia el borde de la caja de Petri. Para las tres cepas catalogadas como T. aggressivum f. europaeum, se observaron las características descritas previamente en la literatura. Se observó que fueron cepas de rápido crecimiento, con formación de conidios al centro (Figura 3B, D y F). Se sabe que la cantidad de conidios puede variar según el medio de cultivo utilizado para su crecimiento, esto pudiera explicar la diferencia en la cantidad de esporas por la presencia del extracto. En las tres cepas no se observó un color amarillento difuso en el medio como cita la literatura; sin embargo, si se observó la formación de pústulas blancas que después cambiaron a color verde, cabe mencionar que el desarrollo de este biotipo Th4 fue el responsable de la epidemia de Trichoderma en Pensilvania (Samuels et al., 2002; Chang y Miles, 2004).
Conclusiones
El extracto de R. graveolens en la concentración de 4 mg/ml en medio de cultivo tuvo un efecto inhibitorio en la velocidad de crecimiento micelial al primer día de las cepas de T. aggressivum f. europaeum CPM-109 de 66%; de 81% para T. aggressivum f. europaeum CPM-112, y 53% para T. aggressivum f. europaeum CPM-113. Las tres cepas de T. aggressivum f. europaeum mostraron resistencia al extracto de R. graveolens en el efecto inhibitorio de la producción de esporas a partir de la prueba de velocidad de crecimiento micelial. Las esporas de las tres cepas de T. aggressivum f. europaeum germinadas directamente sobre medio con extracto de R. graveolens en la prueba de germinación de esporas, se observó un efecto inhibitorio en la germinación y posterior esporulación, con una inhibición mayor a 90% hasta el día 6 para las tres cepas evaluadas. El extracto de R. graveolens disminuyó la densidad del micelio en las cepas de Trichoderma evaluadas.
Agradecimientos
Al Consejo Nacional de Ciencia y Tecnología (CONACYT, México) por el financiamiento de la presente investigación.
Literatura citada
Argumedo-Delira, R.; Alarcón, R.; Ferrera-Cerato, R. y Peña-Cabriales, J. J. 2009. El género fúngico Trichoderma y su relación con contaminantes orgánicos e inorgánicos. Rev. Int. Cont. Amb. 25:257-269. [ Links ]
Chang, S. T. and Miles, P. G. 2004. Mushooms: cultivation, nutritional value, medicinal effect, and environmental impact. 2nd (Ed.). Ed. CC Press. 451 p. [ Links ]
Colina, A.; Ferrer, A. and Urribarri, L. 2009. Cellulase production by Trichoderma reesei Rut C-30 from different cellulosic substrates. Revista Tecnológica de la Universidad de Zulia 32:152-159. [ Links ]
El-Sayed, K.; Mansour, S.; Farouk, S. and Ross, S. A. 2000. New Quinoline Alkaloids from Ruta chalepensis. J. Nat. Products. (63):995-997. [ Links ]
Guzmán, G.; Mata, G.; Salmones, D.; Soto-Velázco, C. y Guzmán-Dávalos, L. 2002. El cultivo de los hongos comestibles. Ed. Instituto Politécnico Nacional. 245 p. [ Links ]
Hale, A. L.; Meepagala, M.; Oliva, A.; Aliotta, G. and Duke, S. O. 2004. Phytotoxins from the leaves of Ruta graveolens. J. Agric. Food Chem. 52:3345-3349. [ Links ]
Kordali, S.; Cakir, A.; Ozer, H.; Cakmakci, R.; Kesdek, M. and Mete, E. 2008. Antifungal, phytotoxic and insecticidal properties of essential oil isolated from Turkish Origanum acutidens and its components, carvacrol, thymol and p-cymene. Biores. Technol. 99:8788-8795. [ Links ]
Oei, P. 1991. Manual of mushroom cultivator. Tool Foundation, Amsterdam. 249 p. [ Links ]
Ojala, T.; Remes, S.; Haansuu, P.; Vuorela, H.; Hiltunen, R.; Haahtela, K. and Vuorela, P. 2000. Antimicrobial activity of some courmain containing herbal plants growing in Finland. J. Ethnopharmacol. 73:299-305. [ Links ]
Oliva, A.; Lahoz, E.; Contillo, R. and Aliotta, G. 1999. Fungistatic activity of Ruta graveolens extract and its allelochemicals. J. Chemical Ecol. 3(25):519-526. [ Links ]
Oliva, A.; Meepagala, K. M.; Wedge, D. E.; Harries, D.; Hale, A. L.; Aliotta, G. and Duke, S. O. 2003. Natural Fungicides from Ruta graveolens L. leaves, including a new quinolone alkaloid. J. Agric. Food Chem. 51:890-896. [ Links ]
Przybylowicz, P. and Donoghue, J. 1990. Shiitake growers handbook. The art and science of Mushroom Cultivation. Ed. Kendall/Hunt Publishing Company. 217 p. [ Links ]
Samuels, G. J.; Dodd, S. L.; Gams, W.; Castlebury, L. A. y Petrini, O. 2002. Trichoderma species associated with the green mold epidemic of commercially grown Agaricus bisporus. Mycología. 94:146-170. [ Links ]
Saxena, J.; Munimbazi, C. y Bullerman, L. B. 2001. Relationship of mould count, ergosterol and ochratoxin A production. Int. J. Food Microbiol. 71:29-34. [ Links ]
Stamets, P. 2000. Growing gourmet and medicinal mushrooms. Ten Speed Press. 3ª ed. 574 p. [ Links ]
Stamets, P. and Chilton, J. S. 1983. The mushroom cultivator. Agarikon Press. 415 p. [ Links ]













